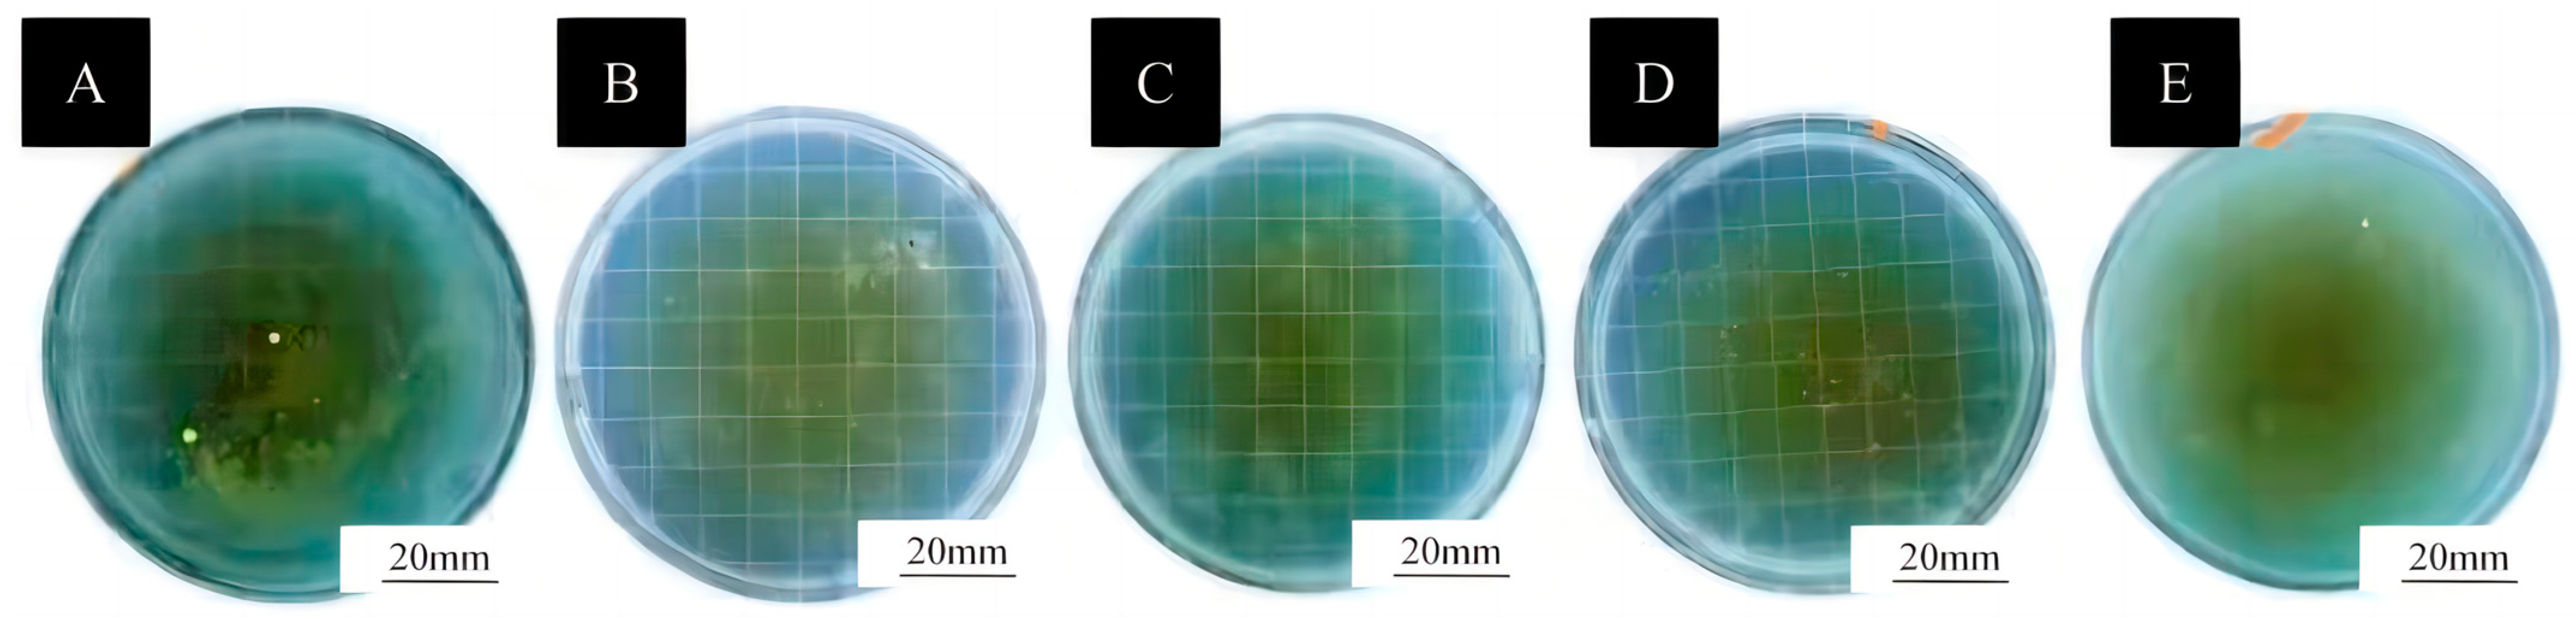
Coatings 15 00517 g008
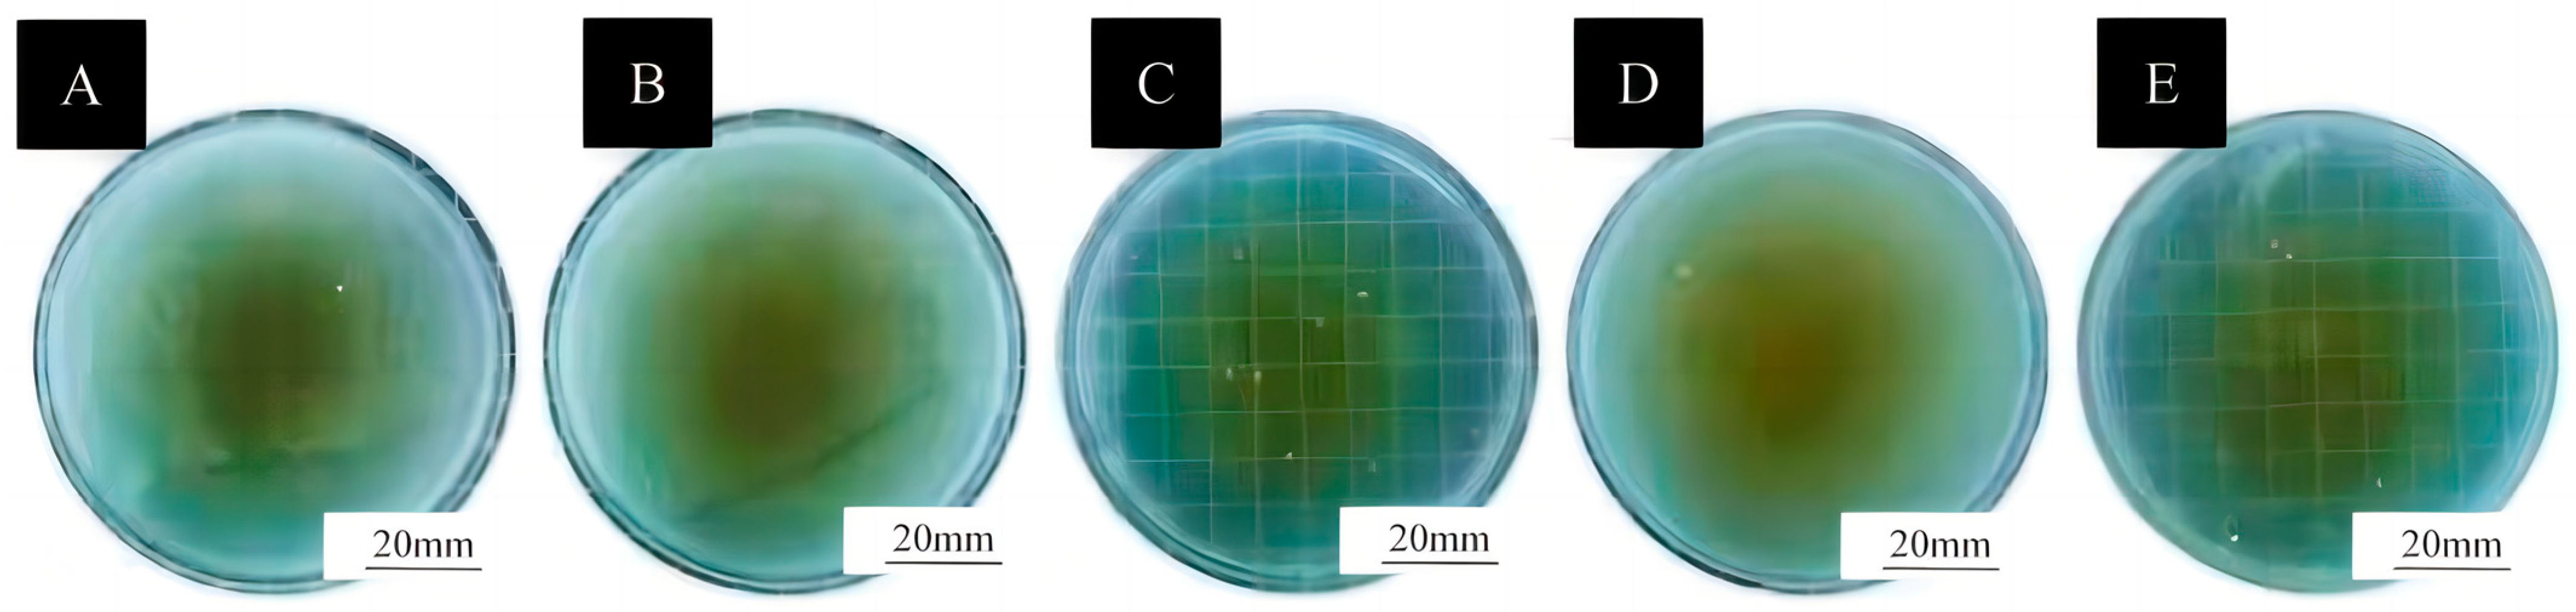
Coatings 15 00517 g009

Development of Chitosan-Coated Tung Oil Microcapsules with Antioxidants from Bamboo Leaves for Enhanced Antimicrobial Waterborne Coatings
Abstract
1. Introduction
2. Test Materials and Methods
2.1. Materials
2.2. Preparation Method of Microcapsules
2.2.1. Preparation Method of Wall Materials
2.2.2. Preparation Method of the Core
2.2.3. Synthesis of Microcapsules
2.3. Painting Method for Basswood
2.4. Testing and Characterisation
2.4.1. Analysis of Microstructure
2.4.2. Analysis of Chemical Composition
2.4.3. Optical Performance Testing
2.4.4. Test Methods for Mechanical Properties of Coatings
2.4.5. Self-Healing Performance Test of Coating
2.4.6. Testing of Antimicrobial Properties of Coatings
3. Results and Discussion
3.1. Analysis of the Morphology and Chemical Composition of Microcapsules
3.1.1. Micromorphometric Analysis of Microcapsules
3.1.2. A Study of the Chemicals in Microcapsules
3.2. Optical Performance Analysis of Coatings
3.3. Mechanical Properties of Coatings
3.3.1. Adhesion of Coatings on Basswood
3.3.2. Hardness of Coatings on Basswood
3.3.3. Impact Resistance of Surface Coating on Basswood
3.4. Self-Healing Rate of Surface Coatings on Basswood
3.5. Antibacterial Properties of Surface Coatings on Basswood
4. Conclusions
Author Contributions
Funding
Institutional Review Board Statement
Informed Consent Statement
Data Availability Statement
Conflicts of Interest
References
- Hisham, F.; Akmal, M.H.M.; Ahmad, F.; Ahmad, K.; Samat, N. Biopolymer Chitosan: Potential Sources, Extraction Methods, and Emerging Applications. Ain Shams Eng. J. 2024, 15, 102424. [Google Scholar] [CrossRef]
- Li, X.X.; Dong, W.J.; Nalin, A.P.; Wang, Y.F.; Pan, P.; Xu, B.; Zhang, Y.B.; Tun, S.; Zhang, J.Y.; Wang, L.S.; et al. The Natural Product Chitosan Enhances the Anti-Tumor Activity of Natural Killer Cells by Activating Dendritic Cells. Oncoimmunology 2018, 7, e1431085. [Google Scholar] [CrossRef]
- Diwu, W.L.; Dong, X.; Nasif, O.; Alharbi, S.A.; Zhao, J.; Li, W. In-vivo Investigations of Hydroxyapatite/Co-polymeric Composites Coated Titanium Plate for Bone Regeneration. Front. Cell Dev. Biol. 2020, 8, 631107. [Google Scholar] [CrossRef]
- Xie, L.; Chen, F.Y.; Tang, Y.B.; Hao, C.C. Tetracycline degradation by persulfate activated with novel magnetic composite ferrocene/chitosan@Fe3O4. J. Chem. Technol. Biotechnol. 2022, 97, 2766–2774. [Google Scholar] [CrossRef]
- Zheng, K.W.; Yang, F.; Huang, Z.H.; Zhan, Y.F.; Xiao, Z.F.; Li, W.; Wang, W.; Qin, C.Q. Preparation of Chitosan Film-Loaded Palladium Catalyst Materials and Their Application in Suzuki Coupling Reactions. J. Mater. Res. Technol. 2022, 20, 3905–3917. [Google Scholar] [CrossRef]
- Sun, X.X.; Yu, D.Y.; Ying, Z.Y.; Pan, C.Q.; Wang, N.; Huang, F.F.; Ling, J.H.; Ouyang, X.K. Fabrication of Ion-Crosslinking Aminochitosan Nanoparticles for Encapsulation and Slow Release of Curcumin. Pharmaceutics 2019, 11, 584. [Google Scholar] [CrossRef]
- Yuan, T.; Guo, X.F.; Shao, S.Y.; An, R.M.; Wang, J.; Sun, J. Characterization and identification of flavonoids from Bambusa chungii leaves extract by UPLC-ESI-Q-TOF-MS/MS. Acta Chromatogr. 2021, 33, 281–294. [Google Scholar] [CrossRef]
- Gong, J.Y.; Xia, D.Z.; Huang, J.; Ge, Q.; Mao, J.W.; Liu, S.W.; Zhang, Y. Functional components of bamboo shavings and bamboo leaf extracts and their antioxidant activities in vitro. J. Med. Food 2015, 18, 453–459. [Google Scholar] [CrossRef] [PubMed]
- Mao, J.W.; Yin, J.; Ge, Q.; Jiang, Z.L.; Gong, J.Y. In vitro antioxidant activities of polysaccharides extracted from Moso Bamboo—Leaf. Int. J. Biol. Macromol. 2013, 55, 1–5. [Google Scholar] [CrossRef]
- Xie, H.K.; Li, A.; Zhao, M.T.; Zhang, M.; Liu, Z.Y.; Yin, F.W.; Liu, X.Y.; Zhou, D.Y.; Shahidi, F.; Zhu, B.W. Effects of antioxidants of bamboo leaves (AOB) on the oxidative susceptibility of glycerophosphocholine and glycerophosphoethanolamine in dried scallop (Argopecten irradians) adductor muscle during storage. LWT—Food Sci. Technol. 2020, 134, 110214. [Google Scholar] [CrossRef]
- Liu, L.Y.; Xia, B.N.; Jin, C.; Zhang, Y.; Zhang, Y. Chemical acylation of water-soluble antioxidant of bamboo leaves (Aob-w) and functional evaluation of oil-soluble AOB (cAob-o). J. Food Sci. 2014, 79, C1886–C1894. [Google Scholar] [CrossRef] [PubMed]
- Shang, Y.F.; Kim, S.M.; Um, B.H. Optimisation of pressurised liquid extraction of antioxidants from black bamboo leaves. Food Chem. 2014, 154, 164–170. [Google Scholar] [CrossRef] [PubMed]
- Ma, X.; Wang, E.P.; Lu, Y.Y.; Wang, Y.; Ou, S.Y.; Yan, R. Acylation of antioxidant of bamboo leaves with fatty acids by lipase and the acylated derivatives’ efficiency in the inhibition of acrylamide formation in fried potato crisps. PLoS ONE 2015, 10, e0130680. [Google Scholar] [CrossRef]
- Liu, L.Y.; Pang, M.R.; Zhang, Y. Lipase-catalyzed regioselective synthesis of flavone C-glucosides esters and high-efficiency oil-soluble antioxidant of bamboo leaves (eAOB-o). Eur. J. Lipid Sci. Technol. 2015, 117, 1636–1646. [Google Scholar] [CrossRef]
- Chaves, J.O.; de Souza, M.C.; da Silva, L.C.; Lachos-Perez, D.; Torres-Mayanga, P.C.; Machado, A.P.D.; Forster-Carneiro, T.; Vázquez-Espinosa, M.; González-de-Peredo, A.V.; Barbero, G.F.; et al. Extraction of flavonoids from natural sources using modern techniques. Front. Chem. 2020, 8, 507887. [Google Scholar] [CrossRef]
- Ma, E.P.; Wei, Z.H.; Lian, C.; Zhou, Y.P.; Gan, S.C.; Xu, B. Preparation of colored microcapsule phase change materials with colored SiO2 shell for thermal energy storage and their application in latex paint coating. Materials 2021, 14, 4012. [Google Scholar] [CrossRef] [PubMed]
- Alencar, D.D.D.; de Souza, E.L.; Almeida, E.T.D.; da Silva, A.L.; Oliveira, H.M.L.; Cavalcanti, M.T. Microencapsulation of Cymbopogon citratus D.C. Stapf Essential Oil with Spray Drying: Development, Characterization, and Antioxidant and Antibacterial Activities. Foods 2022, 11, 1111. [Google Scholar] [CrossRef]
- Zhao, C.; Chen, G.P.; Wang, H.; Zhao, Y.J.; Chai, R.J. Bio-inspired Intestinal Scavenger from Microfluidic Electrospray for Detoxifying Lipopolysaccharide. Bioact. Mater. 2020, 6, 1653–1662. [Google Scholar] [CrossRef]
- Long, M.; Feng, C.; Li, Y.J.; Wang, X.H.; Cai, H.Z.; Zhan, G. Preparation, Characterization and in Vitro Release Characteristics of Sustained-Release Chitosan Microcapsules Containing Tea Tree Oil. Food Sci. 2019, 40, 242–248. [Google Scholar]
- Huang, Z.X.; Wang, Y.L.; Tan, S.J.; Gao, J.M.; Du, L. Preparation, Characterization and Antibacterial Activity of Chitosan-Cinnamon Essential Oil Microcapsules. J. Cellul. Sci. Technol. 2024, 32, 14–22. [Google Scholar]
- Hu, W.G.; Liu, Y.; Konukcu, A.C. Study on withdrawal load resistance of screw in wood-based materials: Experimental and numerical. Wood Mater. Sci. Eng. 2023, 18, 334–343. [Google Scholar] [CrossRef]
- Hu, W.G.; Yu, R.Z. Mechanical and acoustic characteristics of four wood species subjected to bending load. Maderas Cienc. Tecnol. 2023, 25, 39. [Google Scholar] [CrossRef]
- Hu, W.G.; Luo, M.Y.; Hao, M.M.; Tang, B.; Wan, C. Study on the effects of selected factors on the diagonal tensile strength of oblique corner furniture joints constructed by wood dowel. Forests 2023, 14, 1149. [Google Scholar] [CrossRef]
- Liu, Y.; Hu, W.G.; Kasal, A.; Erdil, Y.Z. The State of the Art of Biomechanics Applied in Ergonomic Furniture Design. Appl. Sci. 2023, 13, 12120. [Google Scholar] [CrossRef]
- Hu, W.G.; Luo, M.Y.; Yu, R.Z.; Zhao, Y. Effects of the selected factors on cyclic load performance of T-shaped mortise-and-tenon furniture joints. Wood Mater. Sci. Eng. 2024, 18, 1–10. [Google Scholar] [CrossRef]
- Xu, R.; Wang, D.; Dou, L.H.; Cui, J.Q.; He, L.; Feng, F.Q.; Liu, F.F. Preparation and properties of self-healing polyurethane wood coatings with borate ester bonds. J. For. Eng. 2024, 9, 54–60. [Google Scholar]
- Xu, H.J.; Chen, C.B.; Xiao, J.H.; Pan, J.Q.; Shen, L.M.; Zhang, Y.; Sun, F.L. Effect of chitosan quaternary ammonium salt-modified waterborne epoxy resin on wood dimensional stability and anticorrosion/antimildew properties. J. For. Eng. 2024, 38, 1209–1527. [Google Scholar]
- Wu, Z.H.; Chang, Y.J. Research and application of microcapsule technology in the wood industry. J. For. Eng. 2024, 38, 1029–1345. [Google Scholar]
- Liu, Q.Q.; Gao, D.; Xu, W. Effect of Polyurethane Non-Transparent Coating Process on Paint Film Performance Applied on Modified Poplar. Coatings 2022, 12, 39. [Google Scholar] [CrossRef]
- Xue, J.X.; Xu, W.; Zhou, J.C.; Mao, W.G.; Wu, S.S. Effects of High-Temperature Heat Treatment Modification by Impregnation on Physical And Mechanical Properties of Poplar. Materials 2022, 15, 7334. [Google Scholar] [CrossRef]
- Mai, C.; Schmitt, U.; Niemz, P. A brief overview on the development of wood research. Holzforschung 2022, 75, 102–119. [Google Scholar] [CrossRef]
- Zhang, N.; Xu, W.; Tan, Y. Multi-attribute hierarchical clustering for product family division of customized wooden doors. BioResources 2023, 18, 7889–7904. [Google Scholar] [CrossRef]
- Hu, J.; Liu, Y.; Wang, J.X.; Xu, W. Study of selective modification effect of constructed structural color layers on European beech wood surfaces. Forests 2024, 15, 261. [Google Scholar] [CrossRef]
- Jian, H.; Liang, Y.Q.; Deng, C.; Xu, J.X.; Liu, Y.; Shi, J.Y.; Wen, M.Y.; Park, H.J. Research progress on the improvement of flame retardancy, hydrophobicity, and antibacterial properties of wood surfaces. Polymers 2023, 15, 951. [Google Scholar] [CrossRef]
- Gu, Y.T.; Zhang, J.L. Tensile properties of natural and synthetic rattan strips used as furniture woven materials. Forests 2020, 11, 129. [Google Scholar] [CrossRef]
- Wu, S.S.; Zhou, L.C.; Xu, W. A convenient approach to manufacturing lightweight and high-sound-insulation plywood using furfuryl alcohol/multilayer graphene oxide as a shielding layer. Wood Mater. Sci. Eng. 2024, 19, 1226–1233. [Google Scholar] [CrossRef]
- Liu, Q.Q.; Gao, D.; Xu, W. Influence of the Bottom Color Modification and Material Color Modification Process on the Performance of Modified Poplar. Coatings 2021, 11, 660. [Google Scholar] [CrossRef]
- Su, Y.; Liu, Y.; Hu, J. Impact of wood surface roughness on optical properties of photonic crystal and amorphous photonic crystal structural color coatings. Wood Mater. Sci. Eng. 2024, 19, 1305–1313. [Google Scholar] [CrossRef]
- Weng, M.Y.; Zhu, Y.T.; Mao, W.G.; Zhou, J.C.; Xu, W. Nano-Silica/Urea-Formaldehyde Resin-Modified Fast-Growing Lumber Performance Study. Forests 2023, 14, 1440. [Google Scholar] [CrossRef]
- Wang, C.; Zhang, C.Y.; Zhu, Y. Reverse design and additive manufacturing of furniture protective foot covers. BioResources 2024, 19, 4670–4678. [Google Scholar] [CrossRef]
- Wang, X.Y.; Liu, X.; Wu, S.S.; Xu, W. The influence of different impregnation factors on mechanical properties of silica sol-modified Populus tomentosa. Wood Fiber Sci. 2024, 56, 65–71. [Google Scholar]
- Tampucci, S.; Tofani, G.; Chetoni, P.; Di Gangi, M.; Mezzetta, A.; Paganini, V.; Burgalassi, S.; Pomelli, C.S.; Monti, D. Sporopollenin Microcapsule: Sunscreen Delivery System with Photoprotective Properties. Pharmaceutics 2022, 14, 2041. [Google Scholar] [CrossRef] [PubMed]
- Liu, C.; Xu, W. Effect of Coating Process on Properties of Two-Component Waterborne Polyurethane Coatings for Wood. Coatings 2022, 12, 1857. [Google Scholar] [CrossRef]
- GB/T 11186.3-1989; Method for Measuring the Color of Painted Film—Part 3: Calculation of Color Difference. Standardization Administration of the People’s Republic of China: Beijing, China, 1989.
- GB/T 4893.6-2013; Physical and Chemical Performance Tests of the Paint Film on the Surface of Furniture—Part 6: Method for Determining Gloss. Standardization Administration of the People’s Republic of China: Beijing, China, 2013.
- GB/T 4893.4-2013; Physical and Chemical Performance Tests of the Paint Film on the Surface of Furniture—Part 4: Determination of Adhesion by Cross-Cutting Method. Standardization Administration of the People’s Republic of China: Beijing, China, 2013.
- GB/T 6739-2006; Paints and Varnishes—Determination of Film Hardness by Pencil Method. Standardization Administration of the People’s Republic of China: Beijing, China, 2006.
- GB/T 4893.9-2013; Physical and Chemical Performance Tests of the Paint Film on the Surface of Furniture—Part 9: Determination of Impact Resistance. Standardization Administration of the People’s Republic of China: Beijing, China, 2013.
- GB/T 21866-2008; Test Method for Antibacterial Property and Antibacterial Effect of Antibacterial Coatings (Paint Films). Standardization Administration of the People’s Republic of China: Beijing, China, 2008.
- GB/T 4789.2-2022; Microbiological Examination of Food Hygiene—Aerobic Plate Count. Standardization Administration of the People’s Republic of China: Beijing, China, 2022.
- Shen, Y.; Shan, X.F.; Etim, I.P.; Siddiqui, M.A.; Yang, Y.; Shi, Z.W.; Su, X.P.; Chen, J.X. Comparative study of the effects of nano ZnO and CuO on the biodegradation, biocompatibility, and antibacterial properties of micro-arc oxidation coating of magnesium alloy. Acta Metall. Sin. Engl. 2024, 37, 242–254. [Google Scholar] [CrossRef]
- Zhao, L.R.; Zhang, W.; Wu, Q.; Fu, C.H.; Ren, X.L.; Lv, K.P.; Ma, T.C.; Chen, X.D.; Tan, L.F.; Meng, X.W. Lanthanide Europium MOF Nanocomposite as the Theranostic Nanoplatform for Microwave Thermo-Chemotherapy and Fluorescence Imaging. J. Nanobiotechnol. 2022, 20, 133. [Google Scholar] [CrossRef]
- Wang, C.; Yu, J.H.; Jiang, M.H.; Li, J.Y. Effect of selective enhancement on the bending performance of fused deposition methods 3D-printed PLA models. BioResources 2024, 19, 2660–2669. [Google Scholar] [CrossRef]
- Wang, C.; Zhou, Z.Y. Optical properties and lampshade design applications of PLA 3D printing materials. BioResources 2023, 18, 1545–1553. [Google Scholar] [CrossRef]
- Zhou, J.C.; Xu, W. A fast method to prepare highly isotropic and optically adjustable transparent wood-based composites based on interface optimization. Ind. Crops Prod. 2024, 218, 118898. [Google Scholar] [CrossRef]
- Wang, C.; Zhang, C.Y.; Ding, K.Q.; Jiang, M.H. Immersion polishing post-treatment of PLA 3D printed formed parts on its surface and mechanical performance. BioResources 2023, 18, 7995–8006. [Google Scholar] [CrossRef]

| Test Material | Purity | Manufacturer |
|---|---|---|
| Chitosan with a deacetylation degree of 80.0%–95.0% | AR | Sinopharm Chemical Reagent Co., Ltd., Shanghai, China |
| Acetic acid | AR | Henan Maigao Chemical Co., Ltd., Zhengzhou, China |
| Sodium tripolyphosphate (STPP) | AR | Tianjin Zhonglian Chemical Reagent Co., Ltd., Tianjin, China |
| Tween-80 | AR | Jinan HSBC Chemical Co., Ltd., Jinan, China |
| NaOH | AR | Shandong Xuanhai Chemical Co., Ltd., Weifang, China |
| Anhydrous ethanol | AR | Jinan Hongrun Chemical Co., Ltd., Jinan, China |
| Nutrient agar medium | - | Tianjin Zhonglian Chemical Reagent Co., Ltd., Tianjin, China |
| Nutrient broth | - | Zhongshan Baiwei Biotechnology Co., Ltd., Zhongshan, China |
| Staphylococcus aureus | - | Shanghai Shifeng Biotechnology Co., Ltd., Shanghai, China |
| Escherichia coli | - | Shanghai Shifeng Biotechnology Co., Ltd., Shanghai, China |
| Cleaning agent | AR | Guangdong Baiyun Cleaning Group Co., Ltd., Guangzhou, China |
| Citric acid | AR | Shandong Lemon Biochemical Co., Ltd., Anqiu, China |
| Sample (#) | Chitosan (g) | Antioxidant of Bamboo Leaves (g) | Ethanol (g) | Deionized Water (g) | Tung Oil (g) | Tween-80 (g) | Deionized Water (g) | STPP (g) | Deionized Water (g) |
|---|---|---|---|---|---|---|---|---|---|
| 1 | 1.00 | 0.00 | 1.00 | 99.90 | 0.50 | 0.40 | 39.60 | 0.20 | 19.80 |
| 2 | 0.90 | 0.10 | 0.90 | 89.10 | 0.50 | 0.40 | 39.60 | 0.20 | 19.80 |
| 3 | 0.80 | 0.20 | 0.80 | 79.20 | 0.50 | 0.40 | 39.60 | 0.20 | 19.80 |
| 4 | 0.70 | 0.30 | 0.70 | 69.30 | 0.50 | 0.40 | 39.60 | 0.20 | 19.80 |
| Level | Changes in Coating on Wood Surface |
|---|---|
| 1 | No visible changes (no damage). |
| 2 | No cracks on the surface of the coating, but visible impact marks. |
| 3 | There are mild cracks on the surface of the coating, usually 1–2 circular or arc cracks. |
| 4 | There are moderate to severe cracks on the surface of the coating, usually 3–4 circular or arc cracks. |
| 5 | The surface of the coating is severely damaged, usually with more than 5 cycles of ring cracks, arc cracks, or coating detachment. |
| Sample (#) | Microcapsule Content (%) | Chromaticity Parameter | ∆E | ||
|---|---|---|---|---|---|
| L | a | b | |||
| No microcapsules | 0.0 | 69.6 | 12.6 | 20.3 | 4.78 |
| 66.7 | 16.4 | 20.3 | |||
| 1# microcapsules added | 1.0 | 67.0 | 14.6 | 27.5 | 1.51 |
| 66.2 | 15.6 | 28.3 | |||
| 2# microcapsules added | 1.0 | 66.9 | 28.2 | 58.7 | 31.03 |
| 73.5 | 10.9 | 33.8 | |||
| 3# microcapsules added | 1.0 | 72.6 | 10.9 | 21.6 | 5.76 |
| 72.6 | 10.1 | 15.9 | |||
| 4# microcapsules added | 1.0 | 82.1 | 5.50 | 28.3 | 3.67 |
| 68.2 | 14.7 | 27.0 | |||
| Sample (#) | Microcapsule Content (%) | Glossiness (GU) | Light Loss Rate (%) |
|---|---|---|---|
| 60° | |||
| No microcapsules | 0.0 | 18.5 | - |
| 1# microcapsules | 1.0 | 11.7 | 36.76 |
| 2# microcapsules | 1.0 | 9.7 | 47.57 |
| 3# microcapsules | 1.0 | 13.9 | 24.86 |
| 4# microcapsules | 1.0 | 16.0 | 13.51 |
| Sample (#) | Adhesion Level (Level) |
|---|---|
| No microcapsules | 1 |
| 1# microcapsules | 1 |
| 2# microcapsules | 1 |
| 3# microcapsules | 2 |
| 4# microcapsules | 4 |
| Sample (#) | Hardness |
|---|---|
| No microcapsules | 2H |
| 1# microcapsules | 2B |
| 2# microcapsules | HB |
| 3# microcapsules | 3H |
| 4# microcapsules | 4H |
| Sample (#) | Impact Resistance Level (cm) |
|---|---|
| No microcapsules | 10.0 |
| 1# microcapsules | 10.0 |
| 2# microcapsules | 12.0 |
| 3# microcapsules | 13.0 |
| 4# microcapsules | 15.0 |
| Property | Difference Source | SS | DF | MS | F | p |
|---|---|---|---|---|---|---|
| Hardness | Between Groups | 21.067 | 4 | 5.267 | 19.750 | <0.001 |
| Within Groups | 2.667 | 10 | 0.267 | |||
| Total | 23.733 | 14 | ||||
| Impact Resistance | Between Groups | 43.333 | 4 | 10.833 | 40.625 | <0.001 |
| Within Groups | 2.667 | 10 | 0.267 | |||
| Total | 46.000 | 14 | ||||
| Adhesion | Between Groups | 16.267 | 4 | 4.067 | 61.000 | <0.001 |
| Within Groups | 0.667 | 10 | 0.067 | |||
| Total | 16.933 | 14 | ||||
| Glossiness | Between Groups | 151.123 | 4 | 37.781 | 89.246 | <0.001 |
| Within Groups | 4.233 | 10 | 0.423 | |||
| Total | 155.356 | 14 |
| Sample (#) | Microcapsule Content (%) | Initial Scratch Width (μm) | Scratch Width After 24 h (μm) | Self-Healing Rate (%) |
|---|---|---|---|---|
| No microcapsules | 1.0 | 26.29 | 23.50 | 10.61 |
| 1# microcapsules | 1.0 | 29.09 | 22.05 | 24.20 |
| 2# microcapsules | 1.0 | 44.97 | 42.20 | 6.16 |
| 3# microcapsules | 1.0 | 23.62 | 19.11 | 19.09 |
| 4# microcapsules | 1.0 | 33.63 | 30.97 | 7.91 |
Disclaimer/Publisher’s Note: The statements, opinions and data contained in all publications are solely those of the individual author(s) and contributor(s) and not of MDPI and/or the editor(s). MDPI and/or the editor(s) disclaim responsibility for any injury to people or property resulting from any ideas, methods, instructions or products referred to in the content. |
© 2025 by the authors. Licensee MDPI, Basel, Switzerland. This article is an open access article distributed under the terms and conditions of the Creative Commons Attribution (CC BY) license (https://creativecommons.org/licenses/by/4.0/).
Share and Cite
Zhang, N.; Yan, X. Development of Chitosan-Coated Tung Oil Microcapsules with Antioxidants from Bamboo Leaves for Enhanced Antimicrobial Waterborne Coatings. Coatings 2025, 15, 517. https://doi.org/10.3390/coatings15050517
Zhang N, Yan X. Development of Chitosan-Coated Tung Oil Microcapsules with Antioxidants from Bamboo Leaves for Enhanced Antimicrobial Waterborne Coatings. Coatings. 2025; 15(5):517. https://doi.org/10.3390/coatings15050517
Chicago/Turabian StyleZhang, Nana, and Xiaoxing Yan. 2025. "Development of Chitosan-Coated Tung Oil Microcapsules with Antioxidants from Bamboo Leaves for Enhanced Antimicrobial Waterborne Coatings" Coatings 15, no. 5: 517. https://doi.org/10.3390/coatings15050517
APA StyleZhang, N., & Yan, X. (2025). Development of Chitosan-Coated Tung Oil Microcapsules with Antioxidants from Bamboo Leaves for Enhanced Antimicrobial Waterborne Coatings. Coatings, 15(5), 517. https://doi.org/10.3390/coatings15050517




